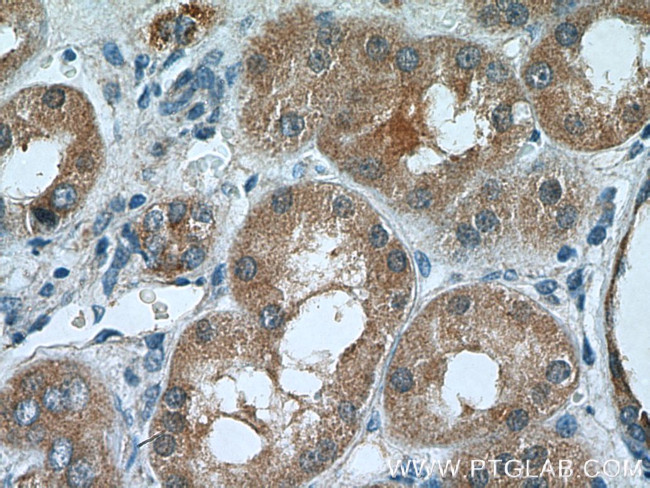
TSTA3 Antibody in Immunohistochemistry (Paraffin) (IHC (P))

Search
Proteintech
TSTA3 Polyclonal Antibody
{{$productOrderCtrl.translations['antibody.pdp.commerceCard.promotion.promotions']}}
{{$productOrderCtrl.translations['antibody.pdp.commerceCard.promotion.viewpromo']}}
{{$productOrderCtrl.translations['antibody.pdp.commerceCard.promotion.promocode']}}: {{promo.promoCode}} {{promo.promoTitle}} {{promo.promoDescription}}. {{$productOrderCtrl.translations['antibody.pdp.commerceCard.promotion.learnmore']}}
产品信息
15335-1-AP
种属反应
宿主/亚型
分类
类型
抗原
偶联物
形式
浓度
规格
纯化类型
保存液
内含物
保存条件
运输条件
产品详细信息
Immunogen sequence: MGEPQGSMR ILVTGGSGLV GKAIQKVVAD GAGLPGEDWV FVSSKDADLT DTAQTRALFE KVQPTHVIHL AAMVGGLFRN IKYNLDFWRK NVHMNDNVLH SAFEVGARKV VSCLSTCIFP DKTTYPIDET MIHNGPPHNS NFGYSYAKRM IDVQNRAYFQ QYGCTFTAVI PTNVFGPHDN FNIEDGHVLP GLIHKVHLAK SSGSALTVWG TGNPRRQFIY SLDLAQLFIW VLREYNEVEP IILSVGEEDE VSIKEAAEAV VEAMDFHGEV TFDTTKSDGQ FKKTASNSKL RTYLPDFRFT PFKQAVKETC AWFTDNYEQA RK (1-321 aa encoded by BC001941)
靶标信息
Tissue specific transplantation antigen P35B is a NADP(H)-binding protein. It catalyze the two-step epimerase and the reductase reactions in GDP-D-mannose metabolism, converting GDP-4-keto-6-D-deoxymannose to GDP-L-fucose. GDP-L-fucose is the substrate of several fucosyltransferases involved in the expression of many glycoconjugates, including blood group ABH antigens and developmental adhesion antigens. Mutations in this gene may cause leukocyte adhesion deficiency, type II.
仅用于科研。不用于诊断过程。未经明确授权不得转售。
篇参考文献 (0)
生物信息学
蛋白别名: 3-5 epimerase/4-reductase; GDP-4-keto-6-deoxy-D-mannose epimerase-reductase; GDP-4-keto-6-deoxy-D-mannose-3,5-epimerase-4-reductase; GDP-fucose synthase; GDP-L-fucose synthase; GDP-L-fucose synthetase; Protein FX; Red cell NADP(H)-binding protein; short chain dehydrogenase/reductase family 4E, member 1; Short-chain dehydrogenase/reductase family 4E member 1; testis tissue sperm-binding protein Li 45a; tissue specific transplantation antigen 3; tissue specific transplantation antigen P35B; Transplantation antigen P35B; Tum-P35B antigen; unnamed protein product
基因别名: AI256181; FX; GFUS; P35B; SDR4E1; TSTA3; Tstap35b
UniProt ID: (Human) Q13630, (Mouse) P23591
Entrez Gene ID: (Human) 7264, (Mouse) 22122, (Rat) 300036